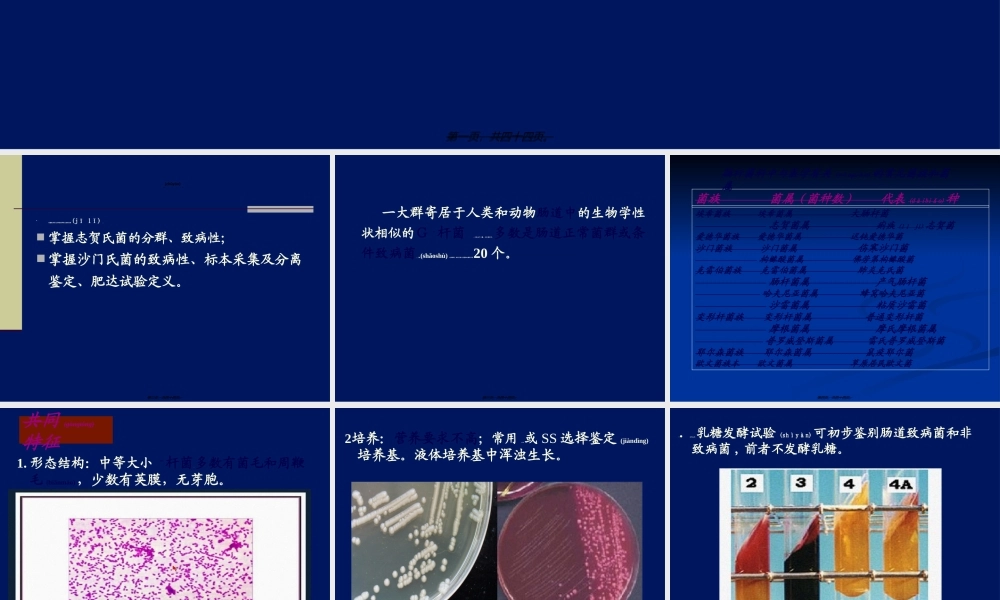
2022年医学专题—第9章-肠道杆菌(1).ppt

第第99章章肠道杆菌肠道杆菌(gǎnjūn)(gǎnjūn)Enterobacteriaceae第一页,共四十四页。主要(zhǔyào)内容掌握致病性大肠杆菌的种类及致病机理(jīlǐ);掌握志贺氏菌的分群、致病性;掌握沙门氏菌的致病性、标本采集及分离鉴定、肥达试验定义。第二页,共四十四页。一大群寄居于人类和动物肠道中的生物学性状相似的G-杆菌,亦存在于土壤、水和腐物中。多数是肠道正常菌群或条件致病菌;少数(shǎoshù)为病原菌,该科引起人类感染的菌种不到20个。第三页,共四十四页。埃希菌族埃希菌属大肠杆菌志贺菌属痢疾(lìji)志贺菌爱德华菌族爱德华菌属迟钝爱德华菌沙门菌族沙门菌属伤寒沙门菌枸橼酸菌属佛劳第枸橼酸菌克雷伯菌族克雷伯菌属肺炎克氏菌肠杆菌属产气肠杆菌哈夫尼亚菌属蜂窝哈夫尼亚菌沙雷菌属粘质沙雷菌变形杆菌族变形杆菌属普通变形杆菌摩根菌属摩氏摩根菌属普罗威登斯菌属雷氏普罗威登斯菌耶尔森菌族耶尔森菌属鼠疫耶尔菌欧文菌族本欧文菌属草原居民欧文菌菌族菌属(菌种数)代表(dàibiǎo)种肠杆菌科中与医学有关(yǒuguān)的常见菌族和菌属第四页,共四十四页。1.形态结构:中等大小G-杆菌,多数有菌毛和周鞭毛(biānmáo),少数有荚膜,无芽胞。共同(gòngtóng)特征第五页,共四十四页。2.培养:营养要求不高;常用EMB或SS选择鉴定(jiàndìng)培养基。液体培养基中浑浊生长。第六页,共四十四页。3.生化反应:乳糖发酵试验(shìyàn)可初步鉴别肠道致病菌和非致病菌,前者不发酵乳糖。第七页,共四十四页。4.抗原结构:主要(zhǔyào)有菌体O抗原,鞭毛H抗原,荚膜K抗原。第八页,共四十四页。综上,对肠道杆菌的鉴定可总结为:(1)形态无特殊,难区分;(2)初步鉴定靠生化反应;(3)最后鉴定靠血清学反应。5.抵抗力:对理化因素(yīnsù)抵抗力不强。6.变异性:S-R变异、耐药性变异等。第九页,共四十四页。第一节埃希菌属第一节埃希菌属(Escherichia)埃希菌属有6个种。其中大肠埃希菌(E.coli)是最常见的临床分离株,是人类重要的条件致病菌,引起肠外感染;另一些血清型的大肠埃希菌具有较强的毒力,能引起肠内感染,导致腹泻(fùxiè)。在环境卫生和食品卫生学中常被用作粪便污染水源,食物的卫生学检测指标。第十页,共四十四页。G-杆菌,多数有周鞭毛和菌毛。营养要求不高,能发酵葡萄糖等多种糖类产酸产气。大多数菌株发酵乳糖(rǔtánɡ)。有O、H和K抗原。抵抗力较强。一、生物学性状(xìngzhuàng)第十一页,共四...